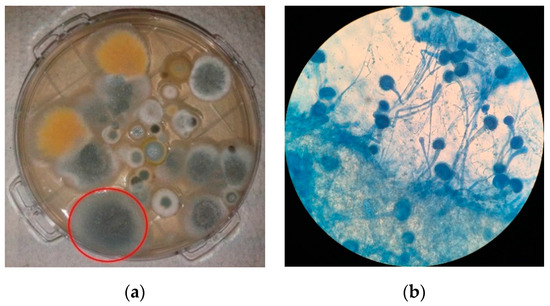

Abstract
Introduction: The frequency in detection of azole-resistant Aspergillus fumigatus isolates has increased since 2010. In Portugal, the section Fumigati is one of the most frequent, and resistant strains to have been found in clinical and environmental contexts. Although several cryptic species within the Fumigati section show intrinsic resistance to azoles, one factor driving (acquired) resistance is selective pressure deriving from the extensive use of azoles. This is particularly problematic in occupational environments where high fungal loads are expected, and where there is an increased risk of human exposure and infection, with impact on treatment success and disease outcome. The mechanisms of resistance are diverse, but mainly associated with mutations in the cyp51A gene. Despite TR34/L98H being the most frequent mutation described, it has only been detected in clinical specimens in Portugal. Methods: We analyzed 99 A. fumigatus isolates from indoor environments (healthcare facilities, spas, one dairy and one waste sorting unit) collected from January 2018 to February 2019 in different regions of Portugal. Isolates were screened for resistance to itraconazole, voriconazole and posaconazole by culture, and resistance was confirmed by broth microdilution. Sequencing of the cyp51A gene and its promoter was performed to detect mutations associated with resistance. Results: Overall, 8.1% of isolates were able to grow in the presence of at least one azole, and 3% (isolated from the air in a dairy and from filtering respiratory protective devices in a waste sorting industry) were pan-azole-resistant, bearing the TR34/L98H mutation. Conclusion: For the first time in Portugal, we report environmental isolates bearing the TR34/L98H mutation, isolated from occupational environments. Environmental surveillance of the emergence of azole-resistant A. fumigatus sensu stricto strains is needed, to ensure proper and timely implementation of control policies that may have a positive impact on public and occupational health.
1. Introduction
The Fumigati section is one of the most prevalent Aspergillus sections, in the clinical context as well as in the environment, in Portugal [1,2,3] and elsewhere [4,5,6,7,8,9,10,11]. They can be isolated from air, water, or soil, and can easily contaminate indoor environments. By producing large numbers of small conidia that can become airborne and be inhaled, they can colonize the upper or lower airways, producing mycotoxicosis, allergies, and invasive infections [12,13,14,15,16,17,18,19]. Immunocompromised individuals are at a higher risk of developing disease or aggravate pre-existing respiratory conditions. This fact is particularly important in healthcare settings, where environmental contamination can result in nosocomial outbreaks of fungal respiratory disease [20,21]. Although infection in immunocompetent individuals is not frequent, exposure to largely contaminated environments as it happens in agriculture, in wood and food (particularly animal) industries, and in waste handling increases the risk of infection.
Exposure to bio aerosols in waste handling and sorting plants and in animal farms has been considered as an occupational health problem. These were the main promoters of several respiratory symptoms, namely decline in lung function, asthma, chronic bronchitis, bronchial hyper-responsiveness, wheezing, and coughing. Disposable filtering respiratory protective devices (FRPDs) regularly worn by these workers may constitute a serious occupational hazard, because water vapor and sweat are released, increasing humidity of the material, and together with high temperature, provide favorable conditions for microorganisms’ growth. Aspergillus fumigatus has been frequently found on the filters of the FRPD, which can be highlighted as a critical occupational risk [22,23,24].
Fumigati cryptic species show intrinsic resistance to several antifungals. However, resistance acquisition in A. fumigatus sensu stricto is emerging due to selective pressure caused by the prolonged azole treatment of chronic aspergillosis patients (that can range from several weeks to years, or even a patient’s full lifetime) or due to environmental selective pressure. The mechanisms of azole resistance are often associated with mutations in genes involved in the A. fumigatus ergosterol pathway [25], particularly in the cyp51A gene which encodes the cytochrome P450 14-α-lanosterol demethylase, the main target of azole antifungals [26]. Point mutations within the cyp51A gene (G54, M220) are more frequently associated with prolonged azole prophylaxis/therapy [27,28]. The most common pan-azole resistance mutation is a combination of a 34-bp long tandem repeat in the promoter region and a leucine-to-histidine substitution in codon 98, TR34/L98H [25,29,30]. This mutation, firstly described in Dutch A. fumigatus isolates, is now spread worldwide [31] due to extensive use of azole fungicides in animal, agricultural, and processing industries.
The selective pressure on A. fumigatus is particularly problematic in environments where the use of azoles is a requirement, such as in agriculture, in preservation industries, and sawmills, where an increased probability of emergence of specific occupational health problems has been observed [32,33]. After infection of azole-naïve individuals with these resistant strains, subsequent treatment failure with triazole therapy (the first choice for treatment and prophylaxis of aspergillosis) may occur [34]. Consequently, higher morbidity and mortality rates associated with azole resistance are likely to become a major public health concern [25,29,34,35].
Monitoring the emergence of resistant A. fumigatus strains to antifungal drugs, particularly to medical triazoles, becomes essential for the adoption of prevention and control strategies with impact in public health. In Portugal, studies have shown that the frequency of azole-resistant A. fumigatus sensu stricto strains is high for itraconazole (ICZ) and posaconazole (PCZ) (up to 92% and 54%, respectively), and lower for voriconazole (VCZ) (up to 3%) [2,3,35]. The TR34/L98H mutation has been detected in Portugal in clinical specimens but, to our knowledge, it has not yet been found on environmental isolates [2,3].
The objective of this study was to assess the frequency of cryptic species belonging to Fumigati section and determine the frequency of azole resistance in A. fumigatus sensu stricto strains isolated from environmental samples. These samples were collected from Portuguese healthcare facilities (hospitals and health centers) and related healthcare environments (thermal spa), and from occupational environments with high fungal loads (waste sorting plants and dairies), where the presence of these fungi may represent a risk for the development of fungal respiratory disease. Our aim was to improve the knowledge of the Fumigati epidemiology in these environmental settings and to understand the molecular mechanisms involved in azole resistance in these isolates.
2. Materials and Methods
2.1. Environmental Sampling
This study was performed using environmental samples collected from January 2018 to February 2019 in different indoor and occupational environments located in several regions of Portugal, with different sampling approaches (Table 1) in the context of enlarged financed studies focusing on occupational exposure to fungi or indoor air quality assessments [22,23,36,37,38,39,40].

Table 1.
Indoor and occupational environments assessed and applied sampling approaches.
Indoor air (50 to 250 L) was collected with a Millipore Air Tester (Millipore, Billerica, MA, USA) using a flow rate of 140 L/min, and impacted directly onto culture media plates, according to the manufacturer’s instructions [39], for the isolation of A. fumigatus (section).
Surface samples were collected by swabbing with a 10 cm × 10 cm square stencil, which was disinfected with a 70% alcohol solution between samplings [39]. Fungal contamination was extracted from the swab by washing with 0.9% NaCl with 0.1% Tween80™, for 30 min at 250 rpm on an orbital laboratory shaker (Edmund Bühler SM-30, Hechingen, Germany) [39]. Wash suspensions were inoculated for A. fumigatus isolation as described below.
Pieces with 2 cm2 (1.4 cm × 1.4 cm) were obtained from filtering respiratory protection devices (FRPDs) and mechanical protection gloves (MPGs) [22,41]. Electrostatic dust collectors (EDC) having a surface exposure area of 0.0209 m (19 × 11 cm) were placed at a minimum 0.93 m above floor level, and dust was allowed to settle on the EDC cloth for 13 to 16 days [37]. Fungal contamination was extracted from the FRPD and MPG pieces, and EDC cloths by washing (as described for surface swabs), and suspensions were inoculated for A. fumigatus isolation as described below.
Settled dust samples were weighted, and 1 g of dust was washed with 9.1 mL of 0.9% NaCl with 0.05% Tween80™, for 60 min at 250 rpm [42]. Wash suspensions were inoculated as below.
2.2. Isolation of Aspergillus Section Fumigati
For Aspergillus isolation, 150 µL of the washing suspensions obtained above were inoculated onto malt extract agar (MEA) supplemented with chloramphenicol (0.05%), dichloran–glycerol agar (DG18), Sabouraud dextrose agar (SDA) and SDA supplemented with either 4 mg/L itraconazole (ICZ), 1 mg/L voriconazole (VCZ), or 0.5 mg/L posaconazole (PCZ) [43]. After incubation at 27 °C for 5 to 7 days, fungal species were identified at section level by macroscopic and microscopic morphology using a tease mount or Scotch tape mount and lactophenol cotton blue mount procedures and using identification atlases [44,45] (Figure 1). Aspergillus fumigatus isolates were selected for further characterization. These procedures followed the algorithm previously suggested to assess the presence of A. fumigatus resistant strains [33].
Figure 1.
Isolation of Aspergillus from air samples: (a) Example of a culture media plate resulting from the collection of indoor air by impaction, and from where Aspergillus section Fumigati (circled red) was isolated; (b) Example of a microscopic (400×) observation of a lactophenol blue mount of an A. fumigatus isolate.
2.3. Molecular Identification of Aspergillus Isolates
Aspergillus fumigatus isolates were confirmed by calmodulin [46] or beta-tubulin [47] sequencing. Briefly, amplifications were performed in a 25 µL volume reaction of Illustra PureTaq Read-to-Go PCR beads (GE Healthcare, Buckinghamshire, UK), containing 15 pmol of the primers cmd5/cmd6 or βtub1/βtub2 (for calmodulin or beta-tubulin amplification, respectively) and 4 µL of Aspergillus genomic DNA extracted with the High Pure PCR Template Preparation Kit (Roche Diagnostics GmbH, Mannheim, Germany) according to the manufacturer’s instructions. Amplifications were carried with the following thermocycling conditions: 1) for calmodulin an initial denaturation at 95 °C for 10 min, followed by 38 cycles of 95 °C for 30 s, 55 °C for 30 s, and 72 °C for 1 min, and a last final extension step of 72 °C for 7 min; 2) for beta-tubulin an initial denaturation at 94 °C for 2 min, followed by 30 cycles of 94 °C for 30 s, 55 °C for 30 s, and 72 °C for 45 s, and a final extension step of 72 °C for 5 min. PCR products were analyzed by electrophoresis through 2% agarose gels and the resultant PCR amplicons were purified using the ExoSAP-IT enzyme system (USB Corporation, Cleveland, OH, USA), according to the manufacturer’s instructions. Sequencing of the forward strand was performed with the BigDye terminator v. 1.1 Cycle sequencing kit (Applied Biosystems) in the thermal cycler with the following conditions: an initial denaturation at 96 °C for 5 s, followed by 30 cycles of 96 °C for 10 s, 50 °C for 5 s and 60 °C for 4 min, followed by one cycle of 72 °C for 5 min. The resultant nucleotide sequences were edited using the program GeneStudio™ Professional Edition v. 2.2.0.0 and aligned with the program MEGA v. 10.0.5. These sequences were compared with sequences deposited in the GenBank database (Bethesda, MD, USA) in order to achieve the identification to species level.
2.4. Screening for Azole-Resistant Isolates
A first characterization of the resistance pattern of the A. fumigatus sensu stricto isolates was carried out using screening media made of Sabouraud dextrose agar supplemented with ICZ, VCZ or PCZ [48]. The reference strain A. fumigatus ATCC 204305 was used as negative control and the pan-azole-resistant strain TR34/L98H (kindly provided by Jacques Meis, Canisius-Wilhelmina Hospital, Nijmegen, The Netherlands) was used as positive control. Strains that were not able to grow in the azole-supplemented plates were considered as susceptible to the respective azoles at tested concentrations, according to EUCAST guidelines [48]. On the other hand, isolates that grew in at least one of the screening media were selected for further analysis.
2.5. Antifungal Susceptibility Testing
The M38-A2 protocol from the Clinical and Laboratory Standards Institute (CLSI) was applied for determining the minimal inhibitory concentrations (MIC) for ICZ, VCZ and PCZ [35,49]. The final concentrations of drugs in the wells ranged from 0.0156 to 8 μg/mL. An internal control strain (A. flavus ATCC 204304) with known susceptibility was included in each run as a positive control of the antifungals’ potency. Sabouraud dextrose agar plates were inoculated with the final inoculum to check the number of colony-forming units in the inoculum. Plates were incubated at 35 °C and examined after 48 h incubation. Absence of visual growth defined the MIC. Breakpoints for mold testing have not been established by the CLSI (breakpoints for voriconazole and A. fumigatus have been set). The CLSI epidemiological cut-off values (ECVs) used were 1 mg/L for ICZ, 1 mg/L for VCZ, and 0.5 mg/L for PCZ [50,51,52]. Isolates with high MICs were tested in triplicate to confirm the obtained results.
2.6. Molecular Identification of Resistance Markers
Azole-resistant isolates were tested by a multiplex real-time PCR which screens for TR34/L98H and TR46/Y121F/T289A mutations found in the cyp51A gene and its promoter (AsperGenius® multiplex real-time PCR assay (PathoNostics, Maastricht, The Netherlands) on the RotorGene Q instrument (Qiagen, Hilden, Germany), following the manufacturer’s instructions), and/or by sequencing of the cyp51A gene and its promoter as described [53,54]. Nucleotide sequences were edited and aligned as described above.
3. Results
A total of 142 environmental samples were studied (Table 2), the majority of which (114, 80.3%) were obtained from the analyzed waste sorting plant.

Table 2.
Number of samples screened per sampling approach and type of indoor/occupational environment assessed, and number of samples positive for Fumigati section.
Aspergillus fumigatus (section) were isolated from all sources studied, particularly from the waste sorting plant (76/114, 66.7%, positive samples) and healthcare units (hospitals/health centers; 19/20, 95.0%, positive samples), for a total of 99/142 (69.7%) isolates. From these, 93/99 (94.0%) were identified as A. fumigatus sensu stricto. For the remaining six isolates, identification to species level was not possible because no PCR product for calmodulin or beta-tubulin sequencing could be obtained. Two isolates, obtained from one air sample from a hospital and from an FRPD from a waste sorting worker, were initially classified as A. fumigatus based on macroscopic and microscopic characteristics and later identified as A. sidowii and Penicillium spp., respectively, by calmodulin sequencing and were not considered in the analysis.
Eight out of the 99 A. fumigatus sensu stricto isolates (8.1%), obtained from air samples from a diary and a hospital, and from FRPDs worn by workers of a waste sorting plant, grew on at least one of the screening media (Table 3). Three isolates (3.0%) were confirmed as resistant to ICZ, VCZ and PCZ, and sequencing of the cyp51A gene and its promoter revealed the TR34/L98H mutation in all three isolates. In addition, the N248K mutation was also detected in two isolates. No other mutations were found.

Table 3.
Growth of resistant A. fumigatus isolates in different screening media, minimal inhibitory concentrations for ICZ, VCZ and PCZ, and mutations found on the cyp51A gene and its promoter.
4. Discussion
The presence of azole-resistant isolates in Portugal has been reported both in clinical specimens and in the environment [2,3,35,55]. To the best of our knowledge, the TR34/L98H mutations, commonly found in the cyp51A gene of azole-resistant isolates, were only reported in clinical specimens in this country. Other mutations in the cyp51A gene were reported in Portuguese environmental azole-resistant A. fumigatus isolates [3], but none undoubtedly described as being associated with resistance. Thus, in this study, we present the first evidence of environmental pan-azole-resistant strains circulating in Portugal harboring the TR34/L98H mutations. These resistant strains were isolated from FRPDs worn by waste sorting workers during their working shift and from one air sample from a dairy, which is a strong indicator of the increased risk of disease to which workers from these environments are exposed.
In one of our research group’s publications [56] the literature on occupational and indoor exposure to Aspergillus and potential health effects associated with that exposure was reviewed. Among the workplaces with high fungal contamination and potentially high levels of mycotoxins, waste sorting plants stand as one of the environments with the highest fungal contamination [57,58]. This is not only due to the type of materials being processed and the consequent availability of nutrients, but also due to the presence of a high concentration of indoor dust particles, to the deposition of waste indoors, and to the building materials, all of which favor fungal growth and sporulation [56].
Aspergillus is also described as one of the most frequent fungi in animal production farms [58,59]. The higher fungal contamination is probably a result of the higher animal density and confined production, conditions that promote the multiplication of microorganisms. Nevertheless, those are not the only sources of contamination, and animal feed and/or animal litter must be considered as potential sources, because their distribution may generate aerosolized particles that remain in the air or are deposited onto the floor for a long time. Cereal-based feed and wood shavings used in bedding can introduce resistant fungal strains into animal production farms. This may happen as a result of the azole pressure exerted in fungal selection, a consequence of the systemic use of azole and azole-based fungicides in the protection of feed crops [60,61] and in wood processing and preservation [32,62]. Although correct management and protection equipment may protect workers in these occupational environments, azole residues are still spread through the environment and can have a negative health impact through their toxicity and persistence in the environment, while boosting the development of azole-resistant fungal strains [63,64].
By working in close contact with these materials, waste sorting and animal production workers are at increased risk of cumulative exposure to fungal particles and mycotoxins, which can reach their respiratory systems and result in occupationally acquired respiratory diseases [56]. Of particular importance, exposure of these workers to azole-resistant isolates may lead to treatment failure, and consequently, significant impact on patient management and associated health costs. Therefore, strategies to prevent or minimize the occupational exposure to Aspergillus become of paramount importance and should include, but not be limited to, the correct use, storage and elimination of personal protective equipment, particularly FRPDs, and the implementation of continuous assessment and characterization of the Aspergillus burden in such environments.
The obtained results also validate a previously proposed algorithm aiming to support and provide guidance from fieldwork in assessed occupational environments (which sampling methods should be applied) to the bench work (what analysis should be performed) for exposure assessors [33]. Thus, in occupational environments where the azole pressure is high, such as vineyards, sawmills, and waste sorting plants, just to name a few, the frequency of cryptic species and of azole resistance of A. fumigatus sensu stricto should be assessed as routine to achieve an accurate risk characterization. In high-load environments, such as in the waste sorting unit and the dairy farm assessed, results are most certainly underestimated; the recovery of the Aspergillus section Fumigati isolates is a challenging task due to overgrowth of other fungi isolates with fast growth rates, such as Mucorales and Chrysonilia sitophila [22,33,37,39,40,42]. Additionally, isolate recovery relies only on the viable component of the fungal contamination. Thus, the culture-based methods drawbacks should be considered [22,33].
Several Fumigati isolates from hospital environments were also analyzed in this study. Despite no mutations having been detected, monitoring these environments for the frequency of cryptic species (intrinsically resistant to azoles) and for the emergence of resistant A. fumigatus strains to antifungal drugs, particularly to medical triazoles, becomes essential for the adoption of prevention and control strategies in order to reduce the mortality associated with these infections in at risk patients.
Azole-resistant A. fumigatus strains will probably become more frequent in the future, as a consequence of natural evolution and by selective pressure due to the use of triazoles in medicine and in the environment, with important public health implications. The widespread use of triazoles, in particular, has become the major driver for the clonal expansion of triazole-resistant A. fumigatus genotypes, particularly at local level [65]. Therefore, the continued surveillance of Aspergillus, both in the clinical and in the occupational environments, at local and regional levels, is of paramount importance for the control of the emergence of resistance and, ultimately, for the prevention of aspergillosis.
Author Contributions
Conceptualization, P.G., C.V. (Cristina Veríssimo), C.V. (Carla Viegas), and R.S.; methodology, P.G., A.M., M.D., B.A., C.V. (Carla Viegas), and R.S.; writing—original draft preparation, P.G.; writing—review and editing, P.G., A.M., L.A.C., C.V. (Cristina Veríssimo), C.V. (Carla Viegas) and R.S.; supervision, R.S.; funding acquisition, C.V. (Carla Viegas) and R.S. All authors have read and agreed to the published version of the manuscript.
Funding
This work was supported by: FCT—Fundação para Ciência e Tecnologia, for funding the project “EXPOsE—Establishing protocols to assess occupational exposure to microbiota in clinical settings” (02/SAICT/2016—Project no. 23222); Instituto Politécnico de Lisboa, Lisboa, Portugal, for funding the project “Waste Workers’ Exposure to Bio-burden through Filtering Respiratory Protective Devices” (IPL/2018/WasteFRPD_ESTeSL); and by Instituto Nacional de Saúde Doutor Ricardo Jorge, Lisboa, Portugal, for funding the project “Programa de Vigilância de Aspergillus”.
Institutional Review Board Statement
Not applicable.
Informed Consent Statement
Not applicable.
Data Availability Statement
The data presented in this study are available on request from the corresponding author. The data are not publicly available due to privacy of sampling locations.
Acknowledgments
H&TRC authors gratefully acknowledge the FCT/MCTES national support through the UIDB/05608/2020 and UIDP/05608/2020. P.G. gratefully acknowledges the support of the ECDC EPIET/EUPHEM Programme, in particular Rita Sousa and Maria João Simões (Site Supervisors) and Loredana Ingrosso and Aftab Jasir (Scientific Coordinators for EUPHEM path).
Conflicts of Interest
The authors declare no conflict of interest.
References
- Sabino, R.; Veríssimo, C.; Parada, H.; Brandão, J.; Viegas, C.; Carolino, E.; Clemons, K.V.; Stevens, D.A. Molecular screening of 246 Portuguese Aspergillus isolates among different clinical and environmental sources. Med. Mycol. 2014, 52, 519–529. [Google Scholar] [CrossRef] [PubMed]
- Pinto, E.; Monteiro, C.; Maia, M.; Faria, M.A.; Lopes, V.; Lameiras, C.; Pinheiro, D. Aspergillus Species and Antifungals Susceptibility in Clinical Setting in the North of Portugal: Cryptic Species and Emerging Azoles Resistance in A. fumigatus. Front. Microbiol. 2018, 9, 1656. [Google Scholar] [CrossRef]
- Monteiro, C.; Pinheiro, D.; Maia, M.; Faria, M.A.; Lameiras, C.; Pinto, E. Aspergillus species collected from environmental air samples in Portugal—Molecular identification, antifungal susceptibility and sequencing of cyp51A gene on A. fumigatus sensu stricto itraconazole resistant. J. Appl. Microbiol. 2019, 126, 1140–1148. [Google Scholar] [CrossRef] [PubMed]
- Rüping, M.; Gerlach, S.; Fischer, G.; Lass-Florl, C.; Hellmich, M.; Vehreschild, J.; Cornely, O.A. Environmental and clinical epidemiology of Aspergillus terreus: Data from a prospective surveillance study. J. Hosp. Infect. 2011, 78, 226–230. [Google Scholar] [CrossRef] [PubMed]
- Mobin, M.; Salmito, M.D.A. Microbiota fúngica dos condicionadores de ar nas unidades de terapia intensiva de Teresina, PI. Rev. Soc. Bras. Med. Trop. 2006, 39, 556–559. [Google Scholar] [CrossRef] [PubMed]
- James, M.J.; Lasker, B.A.; McNeil, M.M.; Shelton, M.; Warnock, D.W.; Reiss, E. Use of a Repetitive DNA Probe to Type Clinical and Environmental Isolates of Aspergillus flavus from a Cluster of Cutaneous Infections in a Neonatal Intensive Care Unit. J. Clin. Microbiol. 2000, 38, 3612–3618. [Google Scholar] [CrossRef]
- Alastruey-Izquierdo, A.; Mellado, E.; Cuenca-Estrella, M. Current section and species complex concepts in Aspergillus: Recommendations for routine daily practice. Ann. N. Y. Acad. Sci. 2012, 1273, 18–24. [Google Scholar] [CrossRef]
- Balajee, S.A.; Kano, R.; Baddley, J.W.; Moser, S.A.; Marr, K.A.; Alexander, B.D.; Andes, D.; Kontoyiannis, D.P.; Perrone, G.; Peterson, S.; et al. Molecular Identification of Aspergillus Species Collected for the Transplant-Associated Infection Surveillance Network. J. Clin. Microbiol. 2009, 47, 3138–3141. [Google Scholar] [CrossRef]
- Krishnan, S.; Manavathu, E.K.; Chandrasekar, P.H. Aspergillus flavus: An emerging non-fumigatus Aspergillus species of significance. Mycoses 2009, 52, 206–222. [Google Scholar] [CrossRef]
- Lortholary, O.; Gangneux, J.-P.; Sitbon, K.; Lebeau, B.; De Monbrison, F.; Le Strat, Y.; Coignard, B.; Dromer, F.; Bretagne, S. Epidemiological trends in invasive aspergillosis in France: The SAIF network (2005–2007). Clin. Microbiol. Infect. 2011, 17, 1882–1889. [Google Scholar] [CrossRef]
- Steinbach, W.J.; Marr, K.A.; Anaissie, E.J.; Azie, N.; Quan, S.-P.; Meier-Kriesche, H.-U.; Apewokin, S.; Horn, D.L. Clinical epidemiology of 960 patients with invasive aspergillosis from the PATH Alliance registry. J. Infect. 2012, 65, 453–464. [Google Scholar] [CrossRef]
- Agarwal, R.; Chakrabarti, A.; Shah, A.; Gupta, D.; Meis, J.F.; Guleria, R.; Moss, R.; Denning, D.W. ABPA complicating asthma ISHAM working group Allergic bronchopulmonary aspergillosis: Review of literature and proposal of new diagnostic and classification criteria. Clin. Exp. Allergy 2013, 43, 850–873. [Google Scholar] [CrossRef]
- Dutre, T.; Al Dousary, S.; Zhang, N.; Bachert, C. Allergic fungal rhinosinusitis—More than a fungal disease? J. Allergy Clin. Immunol. 2013, 132, 487–489. [Google Scholar] [CrossRef]
- Hinojosa, M.; Fraj, J.; De La Hoz, B.; Alcazar, R.; Sueiro, A. Hypersensitivity pneumonitis in workers exposed to esparto grass (Stipa tenacissima) fibers. J. Allergy Clin. Immunol. 1996, 98, 985–991. [Google Scholar] [CrossRef]
- Lai, H.; Mo, X.; Yang, Y.; He, K.; Xiao, J.; Liu, C.; Chen, J.; Lin, Y. Association between aflatoxin B1 occupational airway exposure and risk of hepatocellular carcinoma: A case-control study. Tumor Biol. 2014, 35, 9577–9584. [Google Scholar] [CrossRef]
- Marr, K.A.; Carter, R.A.; Boeckh, M.; Martin, P.; Corey, L. Invasive aspergillosis in allogeneic stem cell transplant recipients: Changes in epidemiology and risk factors. Blood 2002, 100, 4358–4366. [Google Scholar] [CrossRef]
- Matsuse, H.; Tsuchida, T.; Fukahori, S.; Kawano, T.; Nishino, T.; Fukushima, C.; Kohno, S. Dissociation between sensitizing and colonizing fungi in patients with allergic bronchopulmonary aspergillosis. Ann. Allergy Asthma Immunol. 2013, 111, 190–193. [Google Scholar] [CrossRef]
- Rick, E.M.; Woolnough, K.; Pashley, C.H.; Wardlaw, A.J. Allergic Fungal Airway Disease. J. Investig. Allergol. Clin. Immunol. 2016, 26, 344–354. [Google Scholar] [CrossRef]
- Selman, M.; Pardo, A.; King, T.E. Hypersensitivity Pneumonitis. Am. J. Respir. Crit. Care Med. 2012, 186, 314–324. [Google Scholar] [CrossRef]
- Alangaden, G.J. Nosocomial Fungal Infections: Epidemiology, Infection Control, and Prevention. Infect. Dis. Clin. N. Am. 2011, 25, 201–225. [Google Scholar] [CrossRef]
- Godeau, C.; Reboux, G.; Scherer, E.; Laboissiere, A.; Lechenault-Bergerot, C.; Millon, L.; Rocchi, S. Azole-resistant Aspergillus fumigatus in the hospital: Surveillance from flower beds to corridors. Am. J. Infect. Control. 2020, 48, 702–704. [Google Scholar] [CrossRef]
- Viegas, C.; Dias, M.; Almeida, B.; Caetano, L.A.; Carolino, E.; Gomes, A.Q.; Twarużek, M.; Kosicki, R.; Grajewski, J.; Marchand, G.; et al. Are workers from waste sorting industry really protected by wearing Filtering Respiratory Protective Devices? The gap between the myth and reality. Waste Manag. 2020, 102, 856–867. [Google Scholar] [CrossRef]
- Viegas, C.; Twarużek, M.; Dias, M.; Almeida, B.; Carolino, E.; Soszczyńska, E.; Ałtyn, I.; Viegas, S.; Caetano, L.A. Cytotoxic effect of filtering respiratory protective devices from the waste sorting industry: Is in vitro toxicology useful for risk characterization? Environ. Res. 2020, 191, 110134. [Google Scholar] [CrossRef]
- Basinas, I.; Sigsgaard, T.; Heederik, D.; Takai, H.; Omland, Ø.; Andersen, N.T.; Wouters, I.M.; Bønløkke, J.H.; Kromhout, H.; Schlünssen, V. Exposure to inhalable dust and endotoxin among Danish livestock farmers: Results from the SUS cohort study. J. Environ. Monit. 2012, 14, 604–614. [Google Scholar] [CrossRef]
- Van Der Torre, M.H.; Novak-Frazer, L.; Rautemaa-Richardson, R. Detecting Azole-Antifungal Resistance in Aspergillus fumigatus by Pyrosequencing. J. Fungi 2020, 6, 12. [Google Scholar] [CrossRef]
- Pontes, L.; Beraquet, C.A.G.; Arai, T.; Pigolli, G.L.; Lyra, L.; Watanabe, A.; Moretti, M.L.; Schreiber, A. Aspergillus fumigatus Clinical Isolates Carrying CYP51A with TR34/L98H/S297T/F495I Substitutions Detected after Four-Year Retrospective Azole Resistance Screening in Brazil. Antimicrob. Agents Chemother. 2019, 64. [Google Scholar] [CrossRef]
- Chen, J.; Li, H.; Li, R.; Bu, D.; Wan, Z. Mutations in the cyp51A gene and susceptibility to itraconazole in Aspergillus fumigatus serially isolated from a patient with lung aspergilloma. J. Antimicrob. Chemother. 2005, 55, 31–37. [Google Scholar] [CrossRef]
- Escribano, P.; Recio, S.; Peláez, T.; González-Rivera, M.; Bouza, E.; Guinea, J. In Vitro Acquisition of Secondary Azole Resistance in Aspergillus fumigatus isolates after Prolonged Exposure to Itraconazole: Presence of Heteroresistant Populations. Antimicrob. Agents Chemother. 2011, 56, 174–178. [Google Scholar] [CrossRef]
- Pérez-Cantero, A.; López-Fernández, L.; Guarro-Artigas, J.; Capilla, J. Azole resistance mechanisms in Aspergillus: Update and recent advances. Int. J. Antimicrob. Agents 2020, 55, 105807. [Google Scholar] [CrossRef]
- Macedo, D.; Devoto, T.B.; Pola, S.; Finquelievich, J.L.; Cuestas, M.L.; Garcia-Effron, G. A Novel Combination of CYP51A Mutations Confers Pan-Azole Resistance in Aspergillus fumigatus. Antimicrob. Agents Chemother. 2020, 64, e02501-19. [Google Scholar] [CrossRef]
- Dudakova, A.; Spiess, B.; Tangwattanachuleeporn, M.; Sasse, C.; Buchheidt, D.; Weig, M.; Groß, U.; Bader, O. Molecular Tools for the Detection and Deduction of Azole Antifungal Drug Resistance Phenotypes in Aspergillus Species. Clin. Microbiol. Rev. 2017, 30, 1065–1091. [Google Scholar] [CrossRef]
- Jeanvoine, A.; Rocchi, S.; Reboux, G.; Crini, N.; Crini, G.; Millon, L. Azole-resistant Aspergillus fumigatus in sawmills of Eastern France. J. Appl. Microbiol. 2017, 123, 172–184. [Google Scholar] [CrossRef]
- Viegas, C.; Almeida, B.; Caetano, L.A.; Afanou, A.; Straumfors, A.; Veríssimo, C.; Gonçalves, P.; Sabino, R. Algorithm to assess the presence of Aspergillus fumigatus resistant strains: The case of Norwegian sawmills. Int. J. Environ. Health Res. 2020, 1–9. [Google Scholar] [CrossRef]
- European Centre for Disease Prevention and Control (ECDC). Risk Assessment on the Impact of Environmental Usage of Triazoles on the Development and Spread of Resistance to Medical Triazoles in Aspergillus Species. 2013. Available online: https://ecdc.europa.eu/sites/portal/files/media/en/publications/Publications/risk-assessment-impact-environmental-usage-of-triazoles-on-Aspergillus-spp-resistance-to-medical-triazoles.pdf (accessed on 15 February 2019).
- Sabino, R.; Carolino, E.; Veríssimo, C.; Martinez, M.; Clemons, K.V.; Stevens, D.A. Antifungal susceptibility of 175 Aspergillus isolates from various clinical and environmental sources. Med. Mycol. 2016, 54, 740–756. [Google Scholar] [CrossRef]
- Viegas, S.; Assunção, R.; Twaruźek, M.; Kosicki, R.; Grajewski, J.; Viegas, C. Mycotoxins feed contamination in a dairy farm—Potential implications for milk contamination and workers’ exposure in a One Health approach. J. Sci. Food Agric. 2020, 100, 1118–1123. [Google Scholar] [CrossRef]
- Viegas, C.; Twarużek, M.; Lourenço, R.; Dias, M.; Almeida, B.; Caetano, L.A.; Carolino, E.; Gomes, A.Q.; Kosicki, R.; Soszczyńska, E.; et al. Bioburden Assessment by Passive Methods on a Clinical Pathology Service in One Central Hospital from Lisbon: What Can it Tell Us Regarding Patients and Staff Exposure? Atmosphere 2020, 11, 351. [Google Scholar] [CrossRef]
- Viegas, C.; Almeida, B.; Monteiro, A.; Paciência, I.; Rufo, J.; Aguiar, L.; Lage, B.; Gonçalves, L.M.D.; Caetano, L.A.; Carolino, E.; et al. Exposure assessment in one central hospital: A multi-approach protocol to achieve an accurate risk characterization. Environ. Res. 2020, 181, 108947. [Google Scholar] [CrossRef]
- Viegas, C.; Almeida, B.; Monteiro, A.; Caetano, L.A.; Carolino, E.; Gomes, A.Q.; Twarużek, M.; Kosicki, R.; Marchand, G.; Viegas, S. Bioburden in healthcare centers: Is the compliance with Portuguese legislation enough to prevent and control infection? Build. Environ. 2019, 160, 106226. [Google Scholar] [CrossRef]
- Viegas, C.; Dias, M.; Almeida, B.; Carolino, E.; Gomes, A.Q.; Viegas, S. Aspergillus spp. burden on filtering respiratory protective devices. Is there an occupational health concern? Air Qual. Atmos. Health 2020, 13, 187–196. [Google Scholar] [CrossRef]
- Viegas, C.; Twarużek, M.; Dias, M.; Almeida, B.; Carolino, E.; Kosicki, R.; Soszczyńska, E.; Grajewski, J.; Caetano, L.A.; Viegas, S. Assessment of the microbial contamination of mechanical protection gloves used on waste sorting industry: A contribution for the risk characterization. Environ. Res. 2020, 189, 109881. [Google Scholar] [CrossRef]
- Viegas, C.; Almeida, B.; Monteiro, A.; Paciência, I.; Rufo, J.C.; Carolino, E.; Quintal-Gomes, A.; Twarużek, M.; Kosicki, R.; Marchand, G.; et al. Settled dust assessment in clinical environment: Useful for the evaluation of a wider bioburden spectrum. Int. J. Environ. Health Res. 2019, 1–19. [Google Scholar] [CrossRef]
- The European Committee on Antimicrobial Susceptibility Testing (EUCAST). Breakpoint Tables for Interpretation of MICs for Antifungal Agents. 9.0. 2018. Available online: https://www.eucast/clinical_breakpoints/ (accessed on 5 October 2020).
- de Hoog, G.S.; Guarro, J.; Gené, J.; Figueras, M.J. Atlas of Clinical Fungi—The Ultimate Bench Tool for Diagnosis. 4.1; Centraalbureau voor Schimmelcultures: Utrecht, The Netherlands, 2016. [Google Scholar]
- Campbell, C.K.; Johnson, E.M.; Warnock, D.W. Identification of Pathogenic Fungi; Public Health Laboratory Service: London, UK, 1996. [Google Scholar]
- Hong, S.-B.; Go, S.-J.; Shin, H.-D.; Frisvad, J.C.; Samson, R.A. Polyphasic taxonomy of Aspergillus fumigatus and related species. Mycologia 2005, 97, 1316–1329. [Google Scholar] [CrossRef]
- Staab, J.F.; Balajee, S.A.; Marr, K.A. Aspergillus Section Fumigati Typing by PCR-Restriction Fragment Polymorphism. J. Clin. Microbiol. 2009, 47, 2079–2083. [Google Scholar] [CrossRef]
- Guinea, J.; Verweij, P.; Meletiadis, J.; Mouton, J.W.; Barchiesi, F.; Arendrup, M.C.; Arikan-Akdagli, S.; Castanheira, M.; Chryssanthou, E.; Friberg, N.; et al. How to: EUCAST recommendations on the screening procedure E.Def 10.1 for the detection of azole resistance in Aspergillus fumigatus isolates using four-well azole-containing agar plates. Clin. Microbiol. Infect. 2019, 25, 681–687. [Google Scholar] [CrossRef]
- Clinical and Laboratory Standards Institute. M38-A2 Reference Method for Broth Dilution Antifungal Susceptibility Testing of Filamentous Fungi; Approved Standard, 2nd ed.; Clinical and Laboratory Standards Institute: Wayne, PA, USA, 2008. [Google Scholar]
- Clinical and Laboratory Standards Institute. M59 Epidemiological Cutoff Values for Antifungal Susceptibility Testing, 3rd ed.; Clinical and Laboratory Standards Institute: Wayne, PA, USA, 2020. [Google Scholar]
- Buil, J.B.; Hagen, F.; Chowdhary, A.; Verweij, P.E.; Meis, J.F. Itraconazole, Voriconazole, and Posaconazole CLSI MIC Distributions for Wild-Type and Azole-Resistant Aspergillus fumigatus Isolates. J. Fungi 2018, 4, 103. [Google Scholar] [CrossRef]
- Espinel-Ingroff, A.; Diekema, D.J.; Fothergill, A.; Johnson, E.; Pelaez, T.; Pfaller, M.A.; Rinaldi, M.G.; Canton, E.; Turnidge, J. Wild-Type MIC Distributions and Epidemiological Cutoff Values for the Triazoles and Six Aspergillus spp. for the CLSI Broth Microdilution Method (M38-A2 Document). J. Clin. Microbiol. 2010, 48, 3251–3257. [Google Scholar] [CrossRef]
- Prigitano, A.; Venier, V.; Cogliati, M.; De Lorenzis, G.; Esposto, M.C.; Tortorano, A.M. Azole-resistant Aspergillus fumigatus in the environment of northern Italy, May 2011 to June 2012. Eurosurveillance 2014, 19, 20747. [Google Scholar] [CrossRef]
- Mellado, E.; Diaz-Guerra, T.M.; Cuenca-Estrella, M.; Rodriguez-Tudela, J.L. Identification of Two Different 14-α Sterol Demethylase-Related Genes (cyp51A and cyp51B) in Aspergillus fumigatus and Other Aspergillus species. J. Clin. Microbiol. 2001, 39, 2431–2438. [Google Scholar] [CrossRef]
- Monteiro, C.; Faria, M.A.; Pinheiro, D.; Lameiras, C.; Pinto, E. First description of clinical Aspergillus fumigatus cyp51A TR46 /Y121F/T289A mutant in Portugal. J. Glob. Antimicrob. Resist. 2018, 13, 190–191. [Google Scholar] [CrossRef]
- Sabino, R.; Veríssimo, C.; Viegas, C.; Viegas, S.; Brandão, J.; Alves-Correia, M.; Borrego, L.-M.; Clemons, K.V.; Stevens, D.A.; Richardson, M. The role of occupational Aspergillus exposure in the development of diseases. Med. Mycol. 2019, 57, S196–S205. [Google Scholar] [CrossRef]
- Viegas, C.; Gomes, A.Q.; Faria, T.; Sabino, R. Prevalence of Aspergillus fumigatus complex in waste sorting and incineration plants: An occupational threat. Int. J. Environ. Waste Manag. 2015, 16, 353. [Google Scholar] [CrossRef]
- Viegas, C.; Faria, T.; Caetano, L.A.; Carolino, E.; Gomes, A.Q.; Viegas, C. Aspergillus spp. prevalence in different Portuguese occupational environments: What is the real scenario in high load settings? J. Occup. Environ. Hyg. 2017, 14, 771–785. [Google Scholar] [CrossRef] [PubMed]
- Viegas, C.; Faria, T.; Monteiro, A.; Caetano, L.A.; Carolino, E.; Gomes, A.Q.; Viegas, S. A Novel Multi-Approach Protocol for the Characterization of Occupational Exposure to Organic Dust—Swine Production Case Study. Toxics 2017, 6, 5. [Google Scholar] [CrossRef] [PubMed]
- Kano, R.; Kohata, E.; Tateishi, A.; Murayama, S.Y.; Hirose, D.; Shibata, Y.; Kosuge, Y.; Inoue, H.; Kamata, H.; Hasegawa, A. Does farm fungicide use induce azole resistance in Aspergillus fumigatus? Med. Mycol. 2014, 53, 174–177. [Google Scholar] [CrossRef]
- O’Neill, J. Antimicrobials in Agriculture and the Environment: Reducing Unnecessary Use and Waste. The Review on Antimicrobial Resistance. 2015. Available online: https://amr-review.org/sites/default/files/Antimicrobials%20in%20agriculture%20and%20the%20environment%20-%20Reducing%20unnecessary%20use%20and%20waste.pdf (accessed on 1 October 2020).
- Gisi, U. Assessment of selection and resistance risk for demethylation inhibitor fungicides in Aspergillus fumigatus in agriculture and medicine: A critical review. Pest Manag. Sci. 2014, 70, 352–364. [Google Scholar] [CrossRef]
- Chowdhary, A.; Kathuria, S.; Xu, J.; Sharma, C.; Sundar, G.; Singh, P.K.; Gaur, S.N.; Hagen, F.; Klaassen, C.H.; Meis, J.F. Clonal Expansion and Emergence of Environmental Multiple-Triazole-Resistant Aspergillus fumigatus Strains Carrying the TR34/L98H Mutations in the cyp51A Gene in India. PLoS ONE 2012, 7, e52871. [Google Scholar] [CrossRef]
- Verweij, P.E.; Chowdhary, A.; Melchers, W.J.G.; Meis, J.F. Azole Resistance in Aspergillus fumigatus: Can We Retain the Clinical Use of Mold-Active Antifungal Azoles? Clin. Infect. Dis. 2016, 62, 362–368. [Google Scholar] [CrossRef]
- Ashu, E.E.; Hagen, F.; Chowdhary, A.; Meis, J.F.; Xu, J. Global Population Genetic Analysis of Aspergillus fumigatus. MSphere 2017, 2, e00019-17. [Google Scholar] [CrossRef]
Publisher’s Note: MDPI stays neutral with regard to jurisdictional claims in published maps and institutional affiliations. |
© 2020 by the authors. Licensee MDPI, Basel, Switzerland. This article is an open access article distributed under the terms and conditions of the Creative Commons Attribution (CC BY) license (http://creativecommons.org/licenses/by/4.0/).

